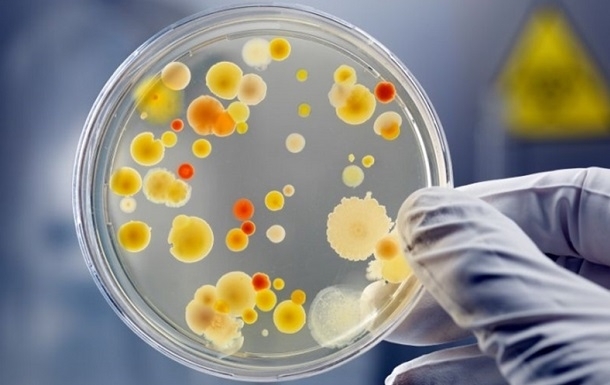

У Краматорську продовжують фіксувати випадки гострих кишкових інфекцій та сальмонельозу. Так, на минулому тижні зареєстровано 5 випадків ГКІ та 2 випадки сальмонельозу. На сальмонельоз захворіли дві дитини – 1 та 9 років. Про це інформує Краматорська районна філія ДУ “Донецький ОЦКПХ МОЗ”. “За результатами щотижневого моніторингу інфекційної захворюваності на гострі кишкові інфекції з 02.06.2023 по 08.06.2023 (23-й тиждень року) зареєстровано 5 випадків гострої кишкової інфекції (ГКІ), інтенсивний показник становить 2,73 на 100 тис. населення та 2 випадки сальмонельозу, визваний Salmonella enteritidis у дітей одного і 9 років. Усі контактні особи у родинному колі обстежені, виявлені два носія збудника S. enteritidis. В структурі захворюваності на кишкові інфекції на цьому тижні гастроентероколіти (ГЕК) з встановленим збудником регіструвались в 80 % випадках і перевищили показник минулого тижня в 3 рази. Аналіз ГКІ на цьому тижні показав домінуючу дію харчового шляху передачі збудників інфекції (80 %). У віковій структурі захворюваності ГКІ превалює захворюваність серед дитячого населення, відсоток складає 80 %. Фахівцями Краматорської районної філії у вогнищах інфекції проведено 7 епідеміологічних обстежень. За їх результатами здійснені відповідні санітарно-протиепідемічні та дезінфекційні заходи”.
У Краматорську продовжують фіксувати випадки гострих кишкових інфекцій та сальмонельозу. Так, на минулому тижні зареєстровано 5 випадків ГКІ та 2 випадки сальмонельозу. На сальмонельоз захворіли дві дитини – 1 та 9 років. Про це інформує Краматорська районна філія ДУ “Донецький ОЦКПХ МОЗ”. “За результатами щотижневого моніторингу інфекційної захворюваності на гострі кишкові інфекції з 02.06.2023 по 08.06.2023 (23-й тиждень року) зареєстровано 5 випадків гострої кишкової інфекції (ГКІ), інтенсивний показник становить 2,73 на 100 тис. населення та 2 випадки сальмонельозу, визваний Salmonella enteritidis у дітей одного і 9 років. Усі контактні особи у родинному колі обстежені, виявлені два носія збудника S. enteritidis. В структурі захворюваності на кишкові інфекції на цьому тижні гастроентероколіти (ГЕК) з встановленим збудником регіструвались в 80 % випадках і перевищили показник минулого тижня в 3 рази. Аналіз ГКІ на цьому тижні показав домінуючу дію харчового шляху передачі збудників інфекції (80 %). У віковій структурі захворюваності ГКІ превалює захворюваність серед дитячого населення, відсоток складає 80 %. Фахівцями Краматорської районної філії у вогнищах інфекції проведено 7 епідеміологічних обстежень. За їх результатами здійснені відповідні санітарно-протиепідемічні та дезінфекційні заходи”.



